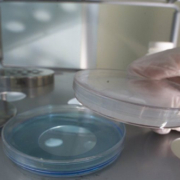

Articolo sulla neutralizzazione dei residui dei disinfettanti
Questa settimana vi segnaliamo un interessante articolo dedicato alla neutralizzazione dei residui di disinfettanti impiegati nelle aree farmaceutiche e sanitarie, scritto da Rolf Muller e Ulrich Eikmanns e pubblicato sull’ultimo numero di #AsccaNews. Buona lettura Neutralizzazione dei residui di disinfettanti impiegati nelle aree farmaceutiche.